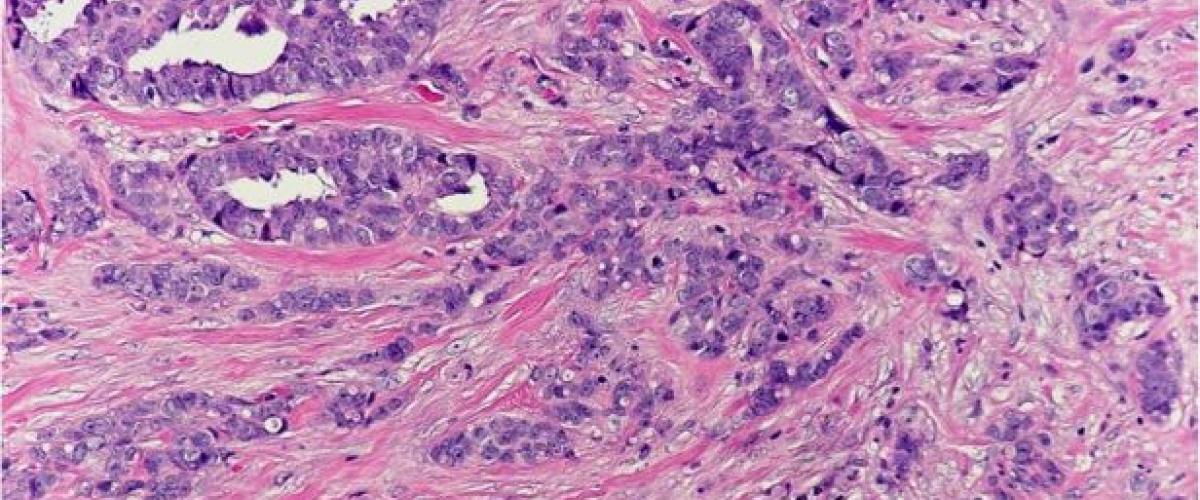
Placeholder

The BRPC digital imaging service offers high quality scanned images of histology slides. We have two state-of-the-art Aperio scanners: the GT-450 and AT-2 scanners, each of which is capable of scanning at an effective ‘40x’ resolution (0.26 um/pixel). Image quality has been demonstrated of sufficient quality for clinical archival purposes. Scanning may be performed on numerous staining modalities, including classic Hematoxylin & Eosin stain, trichrome stain, immunohistochemical stains, and other special stains. Our machines offer high throughput scanning capable of processing up to 81 slides per hour, depending on quantity of tissue per slide, enabling large volume projects for image analysis or development of artificial intelligence/machine learning tools.
In addition to these resources, the BRPC has availability of a machine with the Oncotopix suite of tools available from Visiopharm. These tools can be used for machine learning image analysis, including cell detection, positive cell quantification, and other feature identification from H&E, special stains or immunohistochemical stains. Tissue alignment tools can be used to co-register features between multiple slides, ideally from consecutively cut sections.
Please contact us regarding your pathology imaging analysis project needs at brpc.duke.edu.